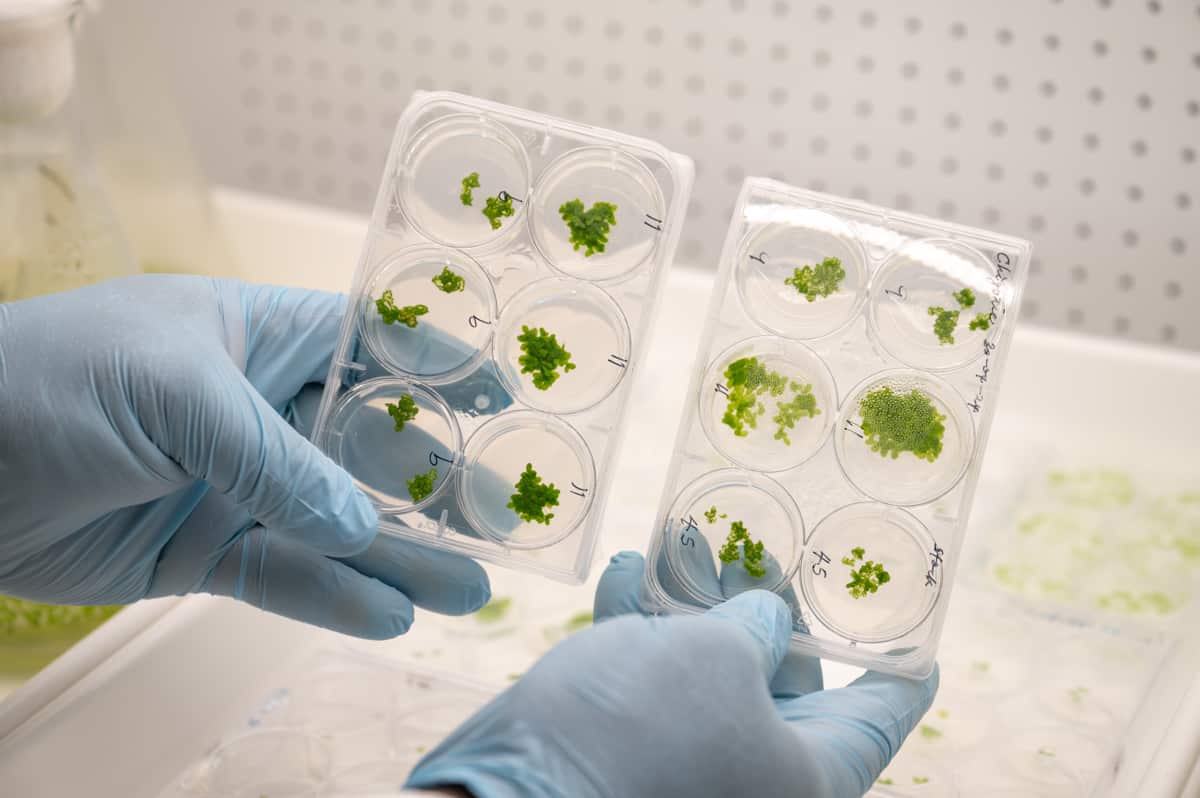
Duckweed Plants for Space credit Naomi Jellicoe-Plants for Space.jpg

ชญาดา พาวเวลส์ –เอสบีเอสไทย
ในอนาคตอันใกล้ คุณอาจพบเจออาหารที่มาในรูปของแคปซูลที่เต็มไปด้วยโภชนาการเลือกได้ พืชผักและเนื้อสัตว์ที่เพาะเลี้ยงเซลล์ในห้องแล็บแนวคิดเหล่านี้ไม่ได้อยู่ในนิยายวิทยาศาสตร์อีกต่อไป หากแต่เป็นบทสนทนาที่เกิดขึ้นจริงในแวดวงนักวิทยาศาสตร์ รัฐบาล และผู้กำหนดนโยบายทั่วโลก
แต่คุณรู้ทราบหรือไม่ว่า ในผืนนาและห้วย หนอง คลอง บึงของประเทศไทยมีอาหารที่เคยถูกมองข้ามจากโลกสมัยใหม่และมันกำลังกลายเป็นคำตอบที่โลกต้องการ
เอสบีเอสไทยพาคุณไปสำรวจว่าทำไมอาหารจากภูมิปัญญาในรากเหง้าของไทยจึงเป็นหลายเป็นหนึ่งในทางออกของอาหารแห่งอนาคต
จากหนองน้ำสู่อวกาศ
ณัฐวุฒิ อินทรกำแหง หรือ “เชฟเต้ย” Executive Chef จากนครแอดิเลดเติบโตมากับ “ไข่ผำ” พืชน้ำขนาดเล็กที่ลอยอยู่ตามห้วย หนอง คลอง บึง ในไร่นาในต่างจังหวัด

เชฟเต้ยเล่าว่าเมื่อตอนเป็นเด็กเขาเคยเดินลุยน้ำตามพ่อแม่ไปจับปลา แล้วเก็บไข่ผำกลับบ้านมาทำกับข้าวบ่อยๆ เขาเล่าว่า
"ผมรู้จักไข่ผำมาตั้งแต่เด็กครับ เป็นเด็กบ้านนอกที่ตามพ่อแม่ไปหาปลาตามหนองบึง แล้วก็เก็บไข่ผำกลับมาทำกับข้าวบางคนก็แค่เก็บพอกิน บางคนเก็บไปขาย"
เมื่อถามถึงรสชาติ เชฟเต้ยบอกว่ามันเหมือนมันคล้ายๆ ผักโขม หรือแกงขี้เหล็กมีรสชาติทั้งขมและหวาน
“มันคล้ายแกงขี้เหล็กนิดๆ มีสีเขียว มีรสขม รสหวาน ปกติมี 2วิธี เขาจะปั้นเป็นก้อนเอาไปนึ่งหรือจะปั้นเป็นก้อนแล้วก็เอาไปต้ม”
และจากอาหารแบบบ้านๆ ไข่ผำ ก็ถูกพัฒนาขึ้นไปอีกขั้น จากโครงการวิจัยไข่ผำของสำนักงานพัฒนาการวิจัยการเกษตรของไทย ที่ค้นพบประโยชน์ด้านโภชนาการที่มี โปรตีน โอเมกา 3 และ 6 สูง และมีคลอโรฟิลล์สูง
ประโยชน์เหล่านี้ได้เตะตานักวิจัยนานาชาติ จนถูกคัดเลือกให้เข้าร่วมโครงการ Plants for Space ซึ่งเป็นความร่วมมือระหว่างมหาวิทยาลัยแอดิเลดและนาซา (NASA) ได้คัดเลือก “ไข่ผำ” ให้เป็นหนึ่งในวัตถุดิบที่มีศักยภาพสูงสำหรับอาหารแห่งอนาคต
และเนื่องจากวัตถุดิบนี้ได้มาจากประเทศไทย โครงการนี้จึงได้มอบหมายให้ เชฟ เต้ย ณัฐวุฒิ ได้นำ “ไข่ผำ” (duckweed) มาทดลองปรุงอาหาร 4 เมนูเพื่อเป็นอาหารสำหรับนักบินอวกาศ
โครงการ Space Food ให้เราทำเมนูจากไข่ผำ 4 เมนู อาหารอนาคตที่กินน้อยแต่มีโภชนาการสูง ผมทำไข่เจียวไข่ผำ แกงอ่อมไข่ผำใส่หมูสามชั้น ไข่ผำเค้ก แล้วก็ไข่ผำคั่วไก่สับณัฐวุฒิ อินทรกำแหง
หลากเมนูจากไขผำที่รังสรรค์โดยเชฟเต้ยจะถูกนำไปแปรรูปเป็นอาหารที่อยู่ในแคปซูลเพื่อความสะดวกในการรับประทานของนักบินอวกาศในสภาวะปลอดแรงโน้มถ่วง
โปรตีนมีขา: เมื่อแมลงไทยเดินทางไกลถึงออสเตรเลีย
ในยุคที่การผลิตเนื้อสัตว์ต้องใช้น้ำและพลังงานมหาศาล แถมยังปล่อยก๊าซเรือนกระจกในปริมาณสูง แถมกินพื้นที่มหาศาล
จึงมีการตั้งคำถามว่า แหล่งโปรตีนจากเนื้อสัตว์ ที่มาจากฟาร์มปศุสัตว์ในระบบอุตสาหกรรมนั้นมีผลกระทบต่อสิ่งแวดล้อมและความยั่งยืนอย่างไร
และคนเริ่มมองหา ‘แหล่งโปรตีนแห่งอนาคต’ ที่ไม่เป็นภาระโลกและธรรมชาติ “แมลง” ก็เป็นทางเลือกหนึ่ง
ที่เมืองชนบทเงียบ ๆ ชื่อสแตนโฮป รัฐวิกตอเรีย ประเทศออสเตรเลีย สามี ภรรยา ไทย-ออสซี พรทิพย์ ชื่นชอบ และ สตีเฟน สเตบบิง เป็นเจ้าของฟาร์มจิ้งหรีดเพื่อขายเป็นอาหารสุดแซ่บของลูกค้าทั่วออสเตรเลีย

พรทิพย์ มีแนวคิดทำฟาร์มเลี้ยงจิ้งหรีดเพื่อเป็นอาหารมนุษย์เมื่อ 6 ปีก่อน เมื่อย้ายมาอยู่ในออสเตรเลียใหม่ๆ เธอเล่าว่า
“เกิดอยากกินจิ้งหรีด วันหนึ่งเห็นจิ้งหรีดกระโดดเข้ามาในบ้าน จึงคิดอยากลองเลี้ยง และไปศึกษาหาข้อมูลดูจากเว็บไซต์บ้าง จากยูทูบบ้าง"
"อยู่เมืองไทยก็ไม่เคยเลี้ยงจิ้งหรีดเลย เพิ่งเคยเลี้ยงเป็นครั้งแรกที่ออสเตรเลีย เริ่มศึกษาเพราะอยากรู้ ก็ได้เรียนรู้จากตรงนี้”
ฟาร์มจิ้งหรีดของพรทิพย์กำลังเติบโตขึ้นในฐานะแหล่งโปรตีนทางเลือกในประเทศที่ผู้คนยังลังเลจะรับประทานแมลง
สตีเฟน สเตบบิง สามีของพรทิพย์ให้ความเห็นว่าจิ้งหรีดจะเป็นแหล่งโปรตีนชั้นดี และใช้ทรัพยากรไม่มากในการเลี้ยง เมื่อเปรียบเทียบกับการเลี้ยงวัวเป็นอาหาร และอยากให้ชาวตะวันตกเปิดใจลอง
“เราควรมองหาโปรตีนจากแหล่งอาหารอื่นๆ ด้วย จากการปล่อยก๊าซเรือนกระจกที่กำลังเป็นปัญหาในปัจจุบัน การเพาะเลี้ยงจิ้งหรีดเพื่อเป็นอาหารนั้นสิ้นเปลืองทรัพยากรน้อยกว่า และปล่อยก๊าซเรือนกระจกน้อยกว่าการเลี้ยงวัวเพื่อกินเนื้อ จึงอยากให้ผู้คนเปิดใจ และหันมาลองกินจิ้งหรีดดูบ้าง”
เสริฟแมลงทอดร้อน ๆ สู่ใจกลางมหานครออสเตรเลีย
จากฟาร์มเลี้ยงจิ้งหรีดในชนบท ที่ส่งโปรตีนแห่งอนาคตถึงหน้าบ้านผู้บริโภคสู่ร้านขายแมลงทอดกรอบ ในย่านที่มีคนพลุกพล่านมากที่สุดแห่งหนึ่งของออสเตรเลีย เช่น ไทยทาวน์ ในนครซิดนีย์

สมพร (จอห์น) โพธิ์ศรี เล่าที่มาของการขายแมลงทอดว่า
“ตอนแรกก็แค่อยากลองขายของที่คนอื่นไม่ขาย ปรากฏว่าขายดี หลักๆ ก็จะมีจิ้งหรีด สะดิ้ง จิ้งโกร่ง ตั๊กแตน หนอนด้วง รถด่วน และดักแด้”
เขาไม่ได้มองแมลงทอดเป็นแค่อาหารแต่มองว่ามันคือสะพานเชื่อมวัฒนธรรมที่เล่าเรื่องของบ้านเกิดให้กับชาวออสซีที่กล้าเปิดใจลิ้มลอง
“คนที่เค้าเคยไปเที่ยวเมืองไทย เคยกินที่เมืองไทยก็มาซื้อกิน คนที่มีแฟนเป็นคนไทย หรือฝรั่งที่มาเป็นกลุ่มมาท้ากันว่ากล้ากินไหม”

การขายแมลงทอดอาจกลายเป็นฑูตทางวัฒนธรรมที่ค่อยๆ เปลี่ยนภาพจำของแมลงในสายตาคนตะวันตก ให้กลายเป็น ‘โปรตีนทางเลือก’ ที่กินได้ง่าย อร่อย และยั่งยืน จอห์น สมพร เล่าว่า
บางทีเค้าก็ซื้อแล้วก็ยืนกินหน้าร้าน ผมก็ไปถามว่าเป็นยังไงกินได้ไหม เค้าบอกตอนแรกก็ไม่กล้ากิน แต่พอกินไปกินมามันก็เหมือนชิพส์ (Chips) กรอบๆ เค็มๆจอห์น สมพร โพธิ์ศรี
ความมั่นคงทางอาหาร ภาวะโลกร้อน ความหลากหลายทางวัฒนธรรม
ศาสตราจารย์ โยฮันเนส เลอ คูตร์ นักวิทยาศาสตร์ผู้ศึกษานวัตกรรมอาหารอนาคตเพื่อสุขภาพจากมหาวิทยาลัยนิวเซาท์เวลส์ (UNSW) และเป็นผู้เขียนบทความ Future of food: what’s on the menu in 2050 บอกกับเอสบีเอสไทยว่า
โลกกำลังเดินทางมาถึงจุดเปลี่ยนที่เราจะต้องคำนึงถึงอาหารแห่งอนาคตเพื่อตอบโจทย์ปัญหาที่มนุษยชาติต้องเผชิญ 2 ประการคือ
food security การมีอาหารพอเพียงต่อมนุษยชาติ และ food safety การมีอาหารที่ปลอดภัย ไม่ปนเปื้อน มีสารอาหารจำเป็นครบถ้วน และไม่ทำลายสุขภาพและสิ่งแวดล้อมในระยะยาว
ภายในปี 2050 เราจะมีคนถึง 10,000 ล้านคนที่ต้องการอาหารและเราต้องแน่ใจว่าอาหารนั้นเพียงพอ มีคุณค่า ปลอดภัยและไม่ทำลายโลกศาสตราจารย์โยฮันเนส เลอ คูตร์

ในมุมมองของศาสตราจารย์โยฮันเนส ความหวังไม่ได้อยู่ที่เทคโนโลยีเพียงอย่างเดียวแต่คือการหยิบภูมิปัญญาจากวัฒนธรรมตะวันออกมาผสานกับวิทยาศาสตร์ตะวันตก
“ในสังคมตะวันตกการกินแมลงยังถูกมองว่าแปลกหลายคนก็รู้สึกขยะแขยง สิ่งสำคัญคือเราต้องสื่อสารให้พวกเขาเข้าใจว่าการกินแมลงเป็นเรื่องปกติและเป็นแหล่งโปรตีนที่ดีต่อสุขภาพโดยไม่ต้องฆ่าสัตว์ใหญ่เพื่อเอาเนื้อมาเป็นอาหาร”
และเปลี่ยนคำถามจาก “เราจะกินอะไร” มาเป็น “เราจะกินอย่างไร“ เพื่ออยู่รอดและอยู่ร่วมกับโลกใบนี้ได้
"อาหารแห่งอนาคตไม่ใช่แค่ต้องมีพอสำหรับคนทั้งโลกแต่ยังต้องมีคุณค่าทางโภชนาการที่ดีต่อร่างกายด้วย อาจมีการนำอาหารพื้นบ้านจากภูมิปัญญาในหลายวัฒนธรรมกลับมารับประทาน"
"จะมีแนวคิดเรื่องโภชนาการเฉพาะบุคคล (personalised nutrition) มากขึ้นผู้คนจะเข้าใจว่าอาหารแบบไหนส่งผลดีกับสุขภาพของตนเอง"
อาหารแห่งอนาคต (Future food) สำหรับบางคนแล้วอาจเป็นคอนเซ็ปต์ที่ไกลตัว แต่จริงๆแล้วมันเป็นเรื่องใกล้ตัวมากกว่าที่คุณคิด
ในวันที่โลกกำลังลุกขึ้นประท้วงจากความต้องการที่ไม่สิ้นสุดของมนุษย์ บางทีทางรอดอาจไม่ใช่การมองไปข้างหน้าเพียงอย่างเดียวแต่อาจเป็นการหันกลับไปรื้อฟื้นภูมิปัญญาและรากเหง้าของเราเองก็เป็นได้...
ฟังสารคดีเรื่องนี้ที่นี่:
ติดตามข่าวสารล่าสุดจากออสเตรเลียและทั่วโลกเป็นภาษาไทยจากเอสบีเอส ไทย ได้ที่ เว็บไซต์ หรือ Facebook และ Instagram








